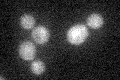
YBR165W
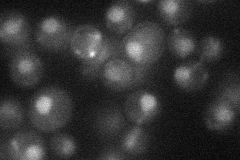
YBR165W
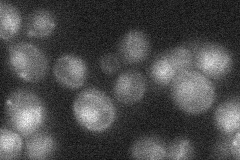
YBR165W
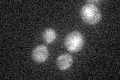
YBR165W
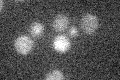
YBR165W

View description
Ubiquitin-conjugating enzyme suppressor that functions as a general positive regulator of Cdc34p activity; nuclear protein that may represent a link between nucleocytoplasmic transport and ubiquitin ligase activity
Localization:
Intensity:
Fold change:
Significance:
-
C’ GFP library in SD
below threshold16.84 -
N' NOP1pr-GFP in SD
punctate,nucleus21.7335 -
N' TEF2pr-mCherry in SD

below threshold5.32664 -
N' NATIVEpr-GFP in SD
punctate,nucleus23.1573 -
N' TEF2pr-VC and Cyto-VN in SD

#N/A0 -
C’ GFP library in SD+DTT

cytosol18.491.09No -
C’ GFP library in SD+H2O2
cytosol181.06No -
C’ GFP library in Starvation Media
cytosol13.890.82No -
C’ GFP library on the background of Pup2-DaMP

below threshold -
C’ GFP library on the background of CCT mutant

below threshold17.60441.04497No
